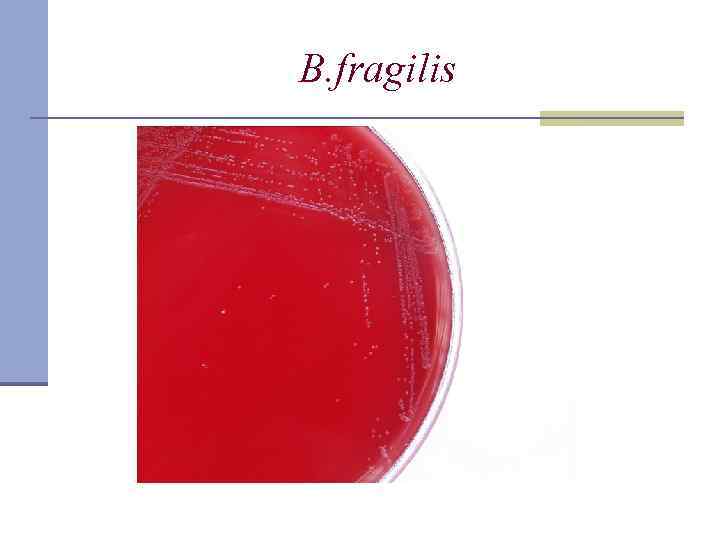
B. fragilis
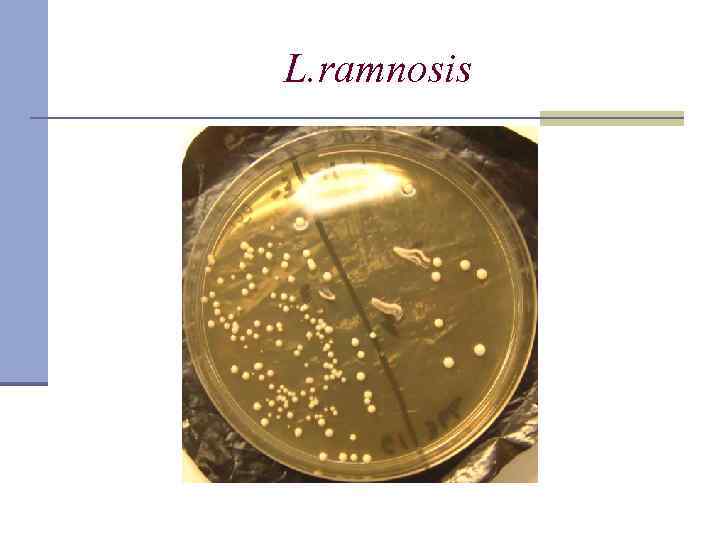
L. ramnosis

4. 1 неспорообразуующие бактерии.ppt
- Количество слайдов: 67

. Неспорообразующие анаэробные бактерии

Частота обнаружения анаэробных бактерий при гнойно-воспалительных Заболеваниях в зависимости от локализации Локализация Челюстно-лицевая область Легкие Органы брюшной полости Женские половые органы Кожа и другие мягкие ткани Опорно-двигательный аппарат Частота обнаружения ( в %) 100 85 70 84 62 -87 39

Грамотрицательные бактерии возбудители анаэробных инфекций n Гр(- )палочки: Fusobacterium spp. (F. nucleatum , F. necrosporum*, F. periodonticum), n Bacteroides fragilis, B. thetaiotaomicron, B. melaninogenicus, , B. gingivalis, B. buccalis, B. denticola, B. endoodontalis, B. asacharolyticus, B. gingivalis, n Prevotella buccae , P. buccalis, P. denticola, P. melaninigenica, P. oralis ( группа), P. oris, P. disiens. n Porphyromonas asacharolitica, P. endodontalis, P. gingivalis n Fusobacterium nucleatum, F. necrosporum, F. periodonticum – n Porphyromonas spp. , n Leptotrichia spp. , Bilophila spp. , Sebaldella spp. , Mitsuokella sp. , Rikenella spp. , n Tisserella spp. , Fibrobacter spp. , Ruminobacter spp. , Desulfomonas spp. n Гр(-) вибрионы Butyrivibrio spp. , Succinovibrio spp. , Anaerovibrio spp. , n Гр(-)кокки: Veillonella spp. (V. alcalescens), Acidaminococcus sp. , Megasphaera spp.

Грамположительные бактерии возбудители анаэробных инфекций n n n n n Гр+ кокки Peptococcus niger Peptostreptococcus (P. magnus , P. asaccharoliticus) Гр+ палочки Lactobacillus spp. ( L. casei, L. rhamnosus, L. alastosus) Eubacterium spp. Propionibacterium spp. Bifidobacterium spp.

Неспорообразующие анаэробы (НОА)представители нормальной микрофлоры Условия для развития инфекции: n Наличие некротизированных тканей n Низкий окислительно-восстановительный потенциал n Нарушение кровоснабжения n И т. д.

Причины дисбактериозов: n Острые кишечные инфекции, паразитарные инвазии n Медикаментозная терапия n Смена диеты –преобладание углеводной или белковой пищи, диеты, Fast. Food n Хронические заболевания ЖКТ n Аллергии n Иммунодефицитные состояния (синдром хронической усталости, стрессы)

Материал для исследования на анаэробы Пораженная область Материал и способ получения l Зубы и синусы Аспират и биоптаты после обработки слизистой провидон-йодом l Легкие Транстрахеальный аспират, легочный аспират l Абдоминальная область Перитонеальная жидкость, пунктат абсцесса l Женские половые органы Лапароскопический материал, операционный материал, аспират после деконтаминации кожи и слизистых l Кости и суставы Биоптаты и пунктат l Мягкие ткани Пунктат после деконтаминации кожи и слизистых, биоптаты, отделяемое из глубоких отделов раны

Правила взятия и доставки материала Тиогликолевая среда с мясным экстрактом 1. Candida albicans 2. Clostridium sprogenes 3. Bacteroides vulgatus 4. Bacillus subtilis 5. Контроль (незасеянная среда)

Метод газо-жидкостной хроматографии

Хроматограмма летучих жирных кислот (ЛЖК) из клинического материала Ребенок (возр. 6 дней)с пневмонией на ИВЛ Ребенок (возр. 7 дней) без пневмонии Хроматограмма ЛЖК в смыве из трахеобронхиального дерева 1. быстрота выполнения 30 -40 мин. 2. высокая информативность ( возможность определения до рода и вида) 3. высокая чувствительностьдо 10 -6 г/л 4. возможность проведения исследования биологических жидкостей при труднодоступной локализации очага 5. возможность контроля эффективности лечения

Хроматограмма чистой культуры B. fragilis А Б А – хроматограмма летучих жирных кислот (ЛЖК) Б – дополнительная уточняющая информация при определении нелетучих жирных кислот (НЭЖК), ароматических кислот и аминов Хроматограмма культуры, выращенной на жидкой питательной среде

Неудачи ГЖХ при диагностике анаэробных и аэробноанаэробных инфекций n Наличие в пробе анаэробов не продуцирующих ЛЖК n n (Bacteroides corridens, Peptococcus magnus, Peptostreptococcus intermedius) Низкая продукция ЛЖК (B. fragilis в случае моноинфекции) Сильное разведение клинического материала (перитонеальная жидкость) Присутствие в пробе аэробов, утилизирующих ЛЖК, выделяемых анаэробами (P. aeruginosa) Присутствие в пробе S. aureus или E. coli, продуцирующих сходные с анаэробами ЛЖК

Характер свечения в УФ n красное - Prevotella melaninogenicus, Porphyromonas asaccharolyticaendodontalis, Veillonella spp. , Clostridium ramosum n зеленое - Clostridium difficile, Clostridium innocuum, Fusobacterium spp. n розовое - бактероиды, стрептококки, стафилококки

Род Bacteroides n Bacteroides fragilis – толстый кишечник, влагалище n B. melaninogenicus n B. oralis ротовая полость Положительная роль: • Сбраживание углеводов • Утилизация белков • Трансформация желчных кислот

Инфекции, вызванные Bacteroides

Bacteroides fragilis

Bacteroides spp.
B. fragilis

Биохимические особенности р. Bacteroides Сбраживают углеводы с образованием : уксусной, изовалериановой, янтарной кислот Каталаза+ Индол+

Биохимические свойства непигментированных бактероидов

Факторы патогенности Bacteroides Патогенетический эффект бактероидов Факторы Лектиноподобные поверхностные белки Полисахаридная капсула ЛПС Каталаза, супероксиддисмутаза Гепариназа Адгезия, подавление фагоцитоза и бактерицидного действия сыворотки, стимуляция к образованию абсцесса Стимуляция провоспалительных цитокинов, лихорадка Аэротолерантность, устойчивость к перекиси Локальные тромбозы + ишемия Протеиназы, липазы, ДНК Инвазия вглубь ткани, ингибируют ПЯЛ -азы, гиалуронидазы Жирные кислоты Ig. A-протеаза Токсическое действие на клетки, в том числе фагоциты (↓ хемотаксис и бактерицидность, вызывают агрегацию тромбоцитов) Разрушение секреторных Ig

Чувствительность p. Bacteroides n Имипенем n Хлорамфеникол n Метронидазол n Карбенициллин

Bacillus сereus

B. сereus

B. сereus

B. сereus

Prevotella melaninogenica, P. intermedia P. oris, P. denticola Ротовая полость, десневой карман, пигменты, красное свечение Выделяют сероводород (запах изо рта больных пародонтозом)

Лечение: устойчивы к Б. лактамам, метронидазолу карбопенемы Инфекция глаза, вызванная Peptostreptococcus prevotii and Prevotella melaninogenica Абсцессы разной локализации

Porphyromonas gingivalis, P. endoodontalis, P. assacharoliticus Мелкие (0, 4 -0, 7 мкм) Гр- палочки, тонкие пили, капсула +, Красное, коралловое свечение в УФ Колонии темно-коричневые на кровяном агаре (накопление гемина) «Живут в кармане» до 50 млн КОЕ Факторы патогенности: фибринолизин, коллагеназа, вызывают агглютинацию эритроцитов Porphyromonas spp. – чувствительны к ванкомицину

p. Fusobacterium n F. nucleatum (палочка Плаута) n F. necrophorum (палочка Шморля) Ротовая полость, толстая кишка 10 мкм

p. Fusobacterium F. nucleatum

Биохимическая активность n Мальтоза + n Сахароза + n Индол + n Каталаза - Масляная кислота

Заболевания, вызываемые представителями р. Fusobacterium n гингиво-стоматит, n ангина Симановского-Венсана (в ассоцияции с трепонемами и боррелиями), n периодонтиты, n поражение мягких тканей головы, шеи n сепсис

Фузобактериоз полости рта nucleatum F.

Гистологический срез печени. Инфекция F. nucleatum Область некроза

F. necrophorum гемолиз

Односторонняя ангина Симановского -Плаута- Венсана F. necrophorum + спирохеты

Факторы патогенности p. Fusobacterium n фосфолипаза А (облегчает инвазию бактерий в глубокие ткани), n лейкоцидин (цитотоксическое действие)

Чувствительность p. Fusobacterium n Хлорамфеникол n Метронидазол n Пенициллин n Цефатоксим

p. Veillonella

Инфекция, вызванная beta-hemolytic Streptococcus and Veillonella

Лабораторная диагностика ГЖХ: n Уксусная к-та n Пропионовая к-та n Красное свечение – естественная флюоресценция

Чувствительность p. Veillonella n Хлорамфеникол n Метронидазол n Клиндамицин

Гр(+) анаэробные кокки n Peptococcus niger n Peptostreptococcus magnus n P. intermedium n P. acnes

р. Peptostreptococcus

р. Peptostreptococcus

Биохимические свойства Peptococcus n Индол – n Каталаза + n Глюкоза – Peptostreptococcus n Индол – n Каталаза – n Глюкоза + (уксусная кислота)

Чувствительность n Пенициллин n Карбенициллин n Левомицетин

Propionibacterium acnes n Гр(+) палочки дифтероидной формы, красная флюоресценция, могут расти в аэробных условиях, 2 недели n Угри, периодонтиты, сепсис, менингиты, артриты, эндоофтальмиты

Инфицирование Propionibacterium acnes кожи

Eubacterium n Грамположительные n n n http: //www. uic. edu/classes/dh/dh 110/Specific%20 Bacteria_files/ slide 0134_image 261. gif n n http: //medecinepharmacie. univ-fcomte. fr/bacterio_web/img/phototheque/ Examens%20 microscopiques/Ana/Eubacterium_nodatum_Culture. jpg полиморфные бактерии (от кокков до длинных палочек) Клетки неправильной формы, с раздутыми или заостренными концами, иногда изогнутые Располагаются одиночно, в парах или цепочках Часто встречаются у детей, находящихся н искусственном вскармливании (до 1010 кл. /г) Похожи на клостридии (в случае слабого спорообразования) Могут причиной оппортунистических инфекций, чаще выделяются при ГСИ ротовой полости, плевритах, пневмониях. инфекционных эндокардитах

p. Bifidobacterium (от лат. bifidus — разделённый надвое) n B. bifibum n B. longum n B. infanis n B. breve

p. Bifidobacterium 2 -5 мкм

Bifidobacterium spp. (B. bifidum, B. adolescentis)

B. breve

Свойства бифидобактерий n Антагонисты к патогенной флоре n Образуют витамины группы В (B 1, B 2 и др. ) и витамин К n Синтезируют аминокислоты и белки n Утилизируют пищевой субстрат n Способствуют усилению всасывания кальция, железа, витамина Д n Иммуномодуляторы n Сбраживают углеводы с образованием уксусной и молочной кислот

p. Lactobacillus n L. delbrueckii – типовой n L. acidophilus n L. casei n Lactobacillus bulgaricus n L. fermenti n L. helveticus n L. lactis n L. leichmannii n L. plantarum

p. Lactobacillus

L. brevis

L. bulgaricus

L. casei
L. ramnosis

p. Lactobacillus

Лактобактерии подавляют рост следующих бактерий: n n n n Bacillus subtilis В. cereus В. stearothermophilus Candida albicans Clostridium perfringes Escherichia coli Klebsiella pneumoniae • Proteus vulgaris • Pseudomonas aeruginosa • P. flourescens • Salmonella typhosa • S. schottmuelleri • Shigella dysenteriae • S. paradysenteriae • Sarcina lutea • Serratia marcescens • Staphylococcus aureus • Streptococcus faecalis • S. lactis • Vibrio comma


Факторы патогенности Bacteroides

4. 1 неспорообразуующие бактерии.ppt